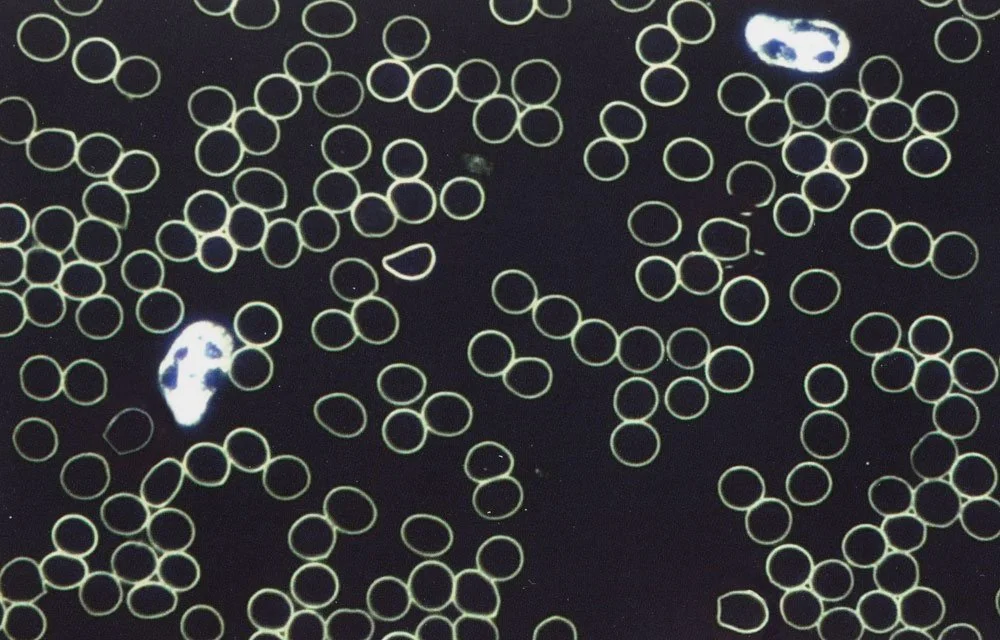

Spezialisierte Naturheilpraxis
für chronische Magen-, Darm- &
Harnwegsbeschwerden
Fühlst du dich gefangen in einem endlosen Zyklus aus Magen-Darm-Problemen oder quälenden Harnwegserkrankungen? Hast du unzählige Einladungen und Termine abgesagt, weil dein Bauch oder deine Blase sich mal wieder gegen dich wendet? Hast du genug von nächtlichen Toilettengängen, die deine Schlafqualität mindern? Sorgst Du dich vor ernsthaften Komplikationen? Stehst du oft isoliert da, weil du "nichts verträgst" und stets dein eigenes Essen mitbringen musst? Verbringst du mehr Zeit auf der Toilette als du möchtest und hast langsam den Glauben verloren, dass es eine Besserung für deine Leiden gibt – nachdem du bereits alles von Medikamenten über Heilkräuter bis hin zu verschiedenen Ernährungsphilosophien ausprobiert hast?
Willkommen auf meiner Seite – ein Ort, wo positive Veränderungen beginnen und du nicht länger alleine bist mit deinen Beschwerden.
Hier in meiner Naturheilpraxis erkunden wir zusammen neue Wege, die über konventionelle Methoden hinausgehen.
Mein Ansatz verbindet die präzisen Einblicke der Dunkelfeldmikroskopie mit den bahnbrechenden Ernährungs- und Entgiftungsstrategien von Anthony William, um einen auf dich persönlich zugeschnittenen Plan zur Förderung deiner Gesundheit zu entwickeln. Dieser Plan umfasst natürliche pflanzliche Mittel, individuell abgestimmte Ernährungspläne und effektive Entgiftungsmethoden – alles mit dem Ziel, das natürliche Gleichgewicht deines Körpers wiederherzustellen und zu stärken.
Ich lade dich ein, den ersten Schritt auf diesem Weg zu machen. Kontaktiere mich für ein Beratungsgespräch, und beginne deine Reise zu einem gesünderen Selbst.
In meiner Praxis bist du nicht nur eine Nummer oder ein weiterer Patient. Wir treten eine gemeinsame Reise an – mit Mitgefühl, Verständnis und der festen Überzeugung, dass eine Verbesserung deiner Gesundheit möglich ist. Deine Geschichte, deine Kämpfe und deine Träume sind hier willkommen. Lass uns gemeinsam daran arbeiten, dir nicht nur Linderung zu verschaffen, sondern eine dauerhafte Besserung zu ermöglichen.
Hallo, mein Name ist Ihya Hrnjadovic.
Als diplomierte Naturheilpraktikerin TEN mit Fokus auf Magen-Darm- und Harnwegsgesundheit habe ich viel von Anthony William gelernt. Seine Methoden haben nicht nur meine Gesundheit grundlegend verbessert, sondern mir auch geholfen, ein tiefgreifendes Verständnis für die Prozesse im Körper zu entwickeln – vor allem dort, wo herkömmliche Medizin oft nicht nachhaltig weiterhelfen konnte und die traditionelle Medizin nicht die erhofften Ergebnisse brachte.
Über fünf Jahre hinweg hat die Anwendung von Anthony Williams Prinzipien in meiner Praxis und meinem persönlichen Leben gezeigt, wie entscheidend sein spezifisches Wissen für die Förderung des körperlichen Gleichgewichts und einer starken Immunabwehr ist. Besonders bei der Behandlung von chronischen Beschwerden im Magen-Darm-Trakt und den Harnwegen hat sich sein Ansatz bewährt.
Ich freue mich darauf, mein Wissen mit dir zu teilen und dich auf deinem Weg zu mehr Autonomie über deine Gesundheit zu begleiten.
Therapien
-
Dunkelfeldmikroskopie
Mit der Dunkelfeld-mikroskopie können feinste Strukturen der Zellen und Mikroorganismen betrachtet werden.
-

Ernährung
Mit einer cleveren Ernährungsstrategie, die alle richtigen Nährstoffe enthält, kann das Immunsystem gestärkt und die Gesundheit gefördert werden.
-

Entgiftung/ Heilkräuter
Entgiftung spielt eine entscheidende Rolle bei der Stärkung des Immunsystems und der Abwehr chronischer Erkrankungen.
-

Nahrungsergänzung
Zielgerichtete Nahrungsergänzung kann dazu beitragen, Nährstoffmängel zu ergänzen.
-

Fettsäure-Analyse
Als akkreditierte Fettsäure-Beraterin biete ich mit einem schnellen Bluttest Einblicke in ihr Fettsäureprofil.
-

Antliz-/Zungendiagnose
Antlitz- und Zungendiagnose bieten ergänzende Einsichten in den allgemeinen Gesundheitszustand.
-

Numerologie
Eine jahrtausendealte Weisheitslehre, wo mithilfe der Zahlen im Geburtsdatum Einblick in persönliche Lebenswege und Stärken aufgezeigt werden kann.
